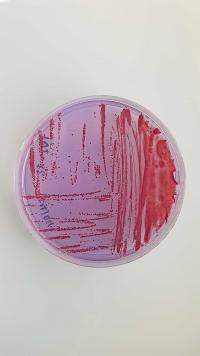

- Accueil
- Dans le monde
- Nos directions régionales
- Réunion, Mayotte et océan Indien
- Actualités
- coopération Cirad Réunion et Polynésie française
La coopération entre le Cirad à La Réunion et la Polynésie Française reboostée !

© Mission sur le terrain menée en Polynésie française par les équipes du Cirad et la Direction de l'agriculture en Polynésie française (© Y. Pecrix, Cirad)
Soumise aux mêmes contraintes d’un territoire insulaire, la Polynésie Française connait les mêmes problématiques d’introductions d’espèces invasives nuisibles aux cultures et d’émergence de maladies que La Réunion. La Réunion et la Polynésie Française partagent les mêmes cultures avec des opportunités de mises en communs des moyens et des efforts en épidémiosurveillance et en stratégies de lutte.
Des travaux partagés pour trouver des solutions au champ
Depuis plusieurs années, afin de répondre à certaines maladies et épidémies communes dans les parcelles maraîchères, le Cirad et la Direction de l’agriculture en Polynésie Française (DAG) renforcent et pérennisent leurs liens. Les interactions sont nombreuses dans les domaines de :
- L’épidémiosurveillance
- Le biocontrôle
- La conservation des ressources génétiques agricoles et naturelles
- La lutte biologique contre les espèces invasives
Afin de couvrir ces différentes thématiques, sept actions sont portées par le projet Epidémiosurveillance et Biocontrôle coordonné par Jean Michel Lett (UMR PVBMT, Cirad à La Réunion) pour évaluer et caractériser l’impact des principales maladies et principaux ravageurs des cultures comme :
- Le flétrissement bactérien sur les principales filières de productions maraîchères
- Les principales viroses des cultures maraîchères et vivrières
- Le Huanglongbing, chancre citrique et chlorose panachée, les principales maladies des agrumes
- La maladie du Wilt de l’ananas « Queen Tahiti »
- Les mouche des fruits et des légumes comme Bactrocera dorsalis
Ce projet se complète également par des actions visant à développer des outils innovants de diagnostic moléculaire de terrain des agents pathogènes et de nouvelles approches de lutte biologique. Par exemple, les outils de diagnostic moléculaire nomade comme la LAMP (loop mediated isothermal amplification) et la lutte biologique à l’aide d’auxiliaires de cultures (prédateurs et parasitoïdes) ou des myco-insecticides, c’est-à-dire, des champignons entomopathogènes présents naturellement dans l’écosystème. Les objectifs de ces actions ont des livrables concrets qui participeront à l’amélioration en qualité et en quantité de la production des principales cultures maraichères, vivrières et horticoles de Polynésie Française.
Une collaboration déjà mise en œuvre et appliquée sur le terrain
Ces thématiques de recherche sont communes et font écho aux problématiques de La Réunion. Elles ont donné lieu à différentes missions de formation et d’expertise afin de renforcer les connaissances, le partage de techniques et de savoir-faire et les actions de transfert-formation. Sur le premier semestre 2023, les échanges et missions ont permis l’étude de la biodiversité en Polynésie Française et l’évaluation des risques liés au complexe d’espèces Ralstonia solanacearum sur les cultures maraichères. Un échantillonnage de plus de 350 échantillons sur les îles de Tahiti et Tubuaï a été réalisé en partenariat entre les équipes Cirad et la DAG. Ces premières actions vont donner lieu à des suites en matière de formation de personnels de la DAG au Pôle de Protection des Plantes en septembre 2023. Des missions de formation sur l’étude des champignons entomopathogènes et leur utilisation en lutte biologique contre les ravageurs des cultures ont également été réalisées ou programmées.
De nouvelles opportunités d’accord en construction
Dans le cadre des multiples collaborations Cirad / DAG, Karima Miri, ingénieure à la DAG de Tahiti a été reçue dans nos locaux en juillet et août 2023. Sa première visite fut l’occasion de découvrir les différentes infrastructures qui composent le pôle de recherche Réunion afin d’envisager un plan d’action de coopération régionale pour développer et enrichir les échanges entre les deux territoires réunionnais et la Polynésie française en matière de recherche agronomique finalisée.
La Réunion et la Polynésie Française sont soumises à des problématiques partagées du fait de leurs caractéristiques communes. Nous avons des travaux en collaboration de longues dates notamment en phytopathologie qui se traduisent par des accueils de chercheurs du Cirad à La Réunion afin de trouver des solutions et partager nos expertises. A l’avenir, nous cherchons à officialiser cette collaboration et mettre en place des échanges plus réguliers de spécialistes pour bénéficier mutuellement des solutions techniques appliquées. Notamment, nous comptons revenir l’année prochaine avec une délégation de professionnels techniques, greffeurs et pépiniéristes, pour suivre des formations sur les techniques de greffage et la conduite de plants sous serres insect-proof. Le renforcement de notre accord cadre permettrait de nouvelles interventions et participerait à la relance des filières fruitières sur notre territoire
Ces activités sont menées en parallèles des activités de coopération scientifique régionale entre le Cirad à La Réunion et les pays membres de la Commission océan Indien (COI). Elles sont organisées autour de réseaux de coopération scientifique que fédère la Plateforme régionale en recherche agronomique pour un développement agricole durable (PRéRAD-OI).